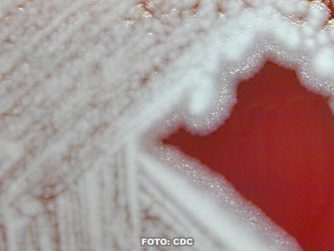

Man hört ja ständig von Mikroplastik, aber wie gefährlich das wirklich für die Umwelt ist, ist noch gar nicht geklärt. Skript: Ist...
In Zukunft könnten Patienten eine Tätowierung mit Nanopartikeln erhalten, die die Konzentration bestimmter Stoffwechselprodukte im Körper...
Auch Kohlmeisen können so eine Art Kultur und Traditionen haben. Aber wie fest sind die verankert? Skript: Progressive Kohlmeisen Wir...
Dass CO2 in der Atmosphäre das Wachstum von Pflanzen anregt, ist ein kleiner Hoffnungsschimmer für die Pläne mit Wiederaufforstung gegen...
Skript: Das menschliche Gehirn ist 1,7 Millionen Jahre alt Für unseren neuen Podcast unternehmen wir eine „Expedition in die...
Transkript: Wann genau das Leben auf der Erde entstand ist unklar. Es gibt einige Indizien die das Alter des Lebens auf etwa dreieinhalb...
Transkript: Mit „Expedition in die Forschung“ – unserem Podcast in Vorbereitung – erkunden wir die Forschungslandschaft und...
Transkript: Komplexe Ökosysteme aus DNA rekonstruieren. Mit unserem neuen Podcast „Expedition in die Forschung“ ziehen wir aus...